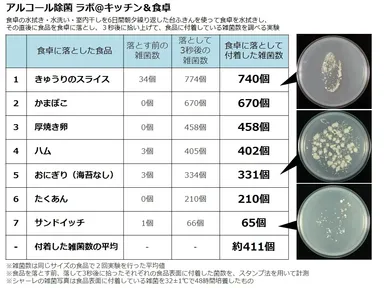
水拭きした後の食卓で、“3秒ルール”を検証

≪食卓の衛生管理 実験レポート≫ 水拭きした後の食卓で、“3秒ルール”を検証
食卓や調理台を拭くなら、水拭きではなく、 ティッシュやキッチンペーパーを使ったアルコール除菌拭きが衛生的!
調査・報告
2014年5月13日 13:00 アルコール除菌 ラボ@キッチン&食卓(事務局:東京都渋谷区)では、2014年4月に衛生微生物研究センターと共同で、台ふきんの雑菌汚染に関する実験を行いましたので、その結果を発表いたします。
<実験結果概要>
●6日間、朝夕繰り返し使った台ふきん(※1)で水拭きすると、食卓には76,000個/10平方センチメートルの雑菌が付着
●その食卓に食べ物を落とすと、わずか3秒でも平均約411個の雑菌が食べ物に付着!
●水拭き後の食卓に落とした食べ物の中で、最も雑菌が付着したのは『きゅうりのスライス』
■背景
梅雨や夏になると気になるのが雑菌の繁殖です。当研究所が特に今回注目しているのが、多くの家庭で行われている台ふきんによる水拭きです。多くのご家庭で行われているシンク脇での室内干しでは、台ふきんの洗い方や干し方によっては、台ふきんの雑菌が増殖してしまうことがあります。雑菌が増殖した台ふきんで食卓や調理台を拭くと、本来であれば清潔にするための水拭きにも関わらず食卓に菌を広げてしまう可能性があります。さらに、その食卓に食べ物を落としてしまったら、その食べ物に雑菌が付着してしまうかもしれません。
そこで、アルコール除菌 ラボ@キッチン&食卓では、衛生微生物研究センターの協力の下、6日間、朝夕繰り返し使用した台ふきん(※1)で拭いた食卓に日常食べる機会の多い食品を落とした場合、わずか3秒でも食卓に落ちていたら、食べ物に雑菌がどの程度付着するのかを実験しました。
(※1) 1週間に1回程度、台ふきんを漂白する家庭を想定し、6日間繰り返し使用した台ふきんで実験を行った。具体的な台ふきんの使用方法は以下の通り。清潔な台ふきんで、食事後を想定した食べカスなどが付着している食卓を水拭き後、台ふきんを水道水でもみ洗いし、水を絞った上で、梅雨時を想定した気温25℃、相対湿度75%の室内環境で自然乾燥させる。同じ台ふきんを使って、食卓の水拭き・水洗い・室内干しを朝夕2回、6日間繰り返した。
■実験方法
STEP(1) 台ふきんで食卓を拭き、水洗い後に室内干しを行う。これを朝夕2回、6日間繰り返す
STEP(2) 台ふきんで清潔な食卓(菌数:検出限界以下)を水拭き後に食卓表面の雑菌を採取し、菌数を計測する
STEP(3) 水拭きした食卓に、食べ物を落として3秒後に拾い上げる
STEP(4) 落とす前、落として3秒後に拾ったそれぞれの食品表面に付着した菌数を、スタンプ法を用いて計測
食卓に落とした食べ物(7品):
おにぎり(海苔なし)、サンドイッチ、厚焼き卵、かまぼこ、ハム、きゅうりのスライス、たくあん
■調査結果
(1)水洗いと室内干しを繰り返した台ふきんで水拭きすると、
食卓に76,000個/10平方センチメートルの雑菌が付着!
水洗いと室内干しを朝夕6日間繰り返した台ふきんで、消毒をした清潔な食卓(菌数:検出限界以下)を水拭きすると、76,000個/10平方センチメートルの雑菌が食卓に付着しており、食卓をきれいにするどころか、雑菌を広げてしまう結果となりました。
画像:食卓の水拭き・水洗い・室内干しを6日間朝夕繰り返した台ふきんで水拭き後の食卓表面から採取した雑菌
※食卓の雑菌を32±1℃で48時間培養したもの
http://www.atpress.ne.jp/releases/46250/img_46250_5.jpg
(2)水洗いと室内干しを繰り返した台ふきんで水拭きした食卓に
食べ物を落とすと、平均約411個の雑菌が食べ物に付着。
水分の多い食べ物は特に要注意!
台ふきんで水拭きし、雑菌で汚染された食卓に食べ物を落としたところ、平均411個の雑菌が食べ物に付着していました。特に、「きゅうりのスライス」(740個)や「かまぼこ」(670個)には多くの雑菌が付着していました。また、お昼時の定番、「おにぎり」と「サンドイッチ」では、「おにぎり」(331個)に対して、「サンドイッチ」は65個の雑菌が付着しました。水分が多く、表面が湿っている食べ物の方が、雑菌が多く付着していました。
表:食卓に落とした食べ物の雑菌数
http://www.atpress.ne.jp/releases/46250/img_46250_1.jpg
■結果考察
水拭き後の食卓に食べ物を落とし、3秒後拾い上げると、今回試したすべての食品で雑菌が付着する結果となりました。今回、試した食品では、水分が多い「きゅうりのスライス」や「かまぼこ」などの食品に、多くの雑菌が付着していました。
食品に雑菌を付けないためにも、清潔な台ふきんで食卓を拭くことをお勧めします。今回の実験のような、水洗いと室内干しを何日も繰り返した台ふきんで食卓を水拭きすると、食卓をキレイにするどころか雑菌を広げているおそれがあります。
■清潔な環境への提案
台ふきんを洗った後に干しておくだけでは、菌が残っている可能性があります。菌を広げるのを避けるためにも、使用後の台ふきんは漂白、天日干しにしましょう。毎日、漂白するのは手間がかかると感じる場合は、台ふきんを乾かした後、アルコール除菌剤をスプレーして除菌するのがおすすめです。
食卓や調理台を拭く際は、きちんと除菌された台ふきんを使いましょう。さらに簡単・手軽にすませたい方には、ティッシュやキッチンペーパーを使った“アルコール除菌拭き”をおすすめします。使い捨てなので衛生的で、しかも高濃度アルコールが水拭きしただけでは取りきれない菌まで除去し、食卓、調理台を清潔にします。
なお、今回の実験で使用し、76,000個/10平方センチメートルの雑菌が付着している食卓を、ティッシュでアルコール除菌拭きしたところ、食卓表面上の雑菌数は検出限度以下となり、除菌がしっかりできていることを確認しました。食卓や調理台を拭くなら、ティッシュやキッチンペーパーを使ったアルコール除菌拭きが衛生的です。
アルコール除菌 ラボ@キッチン&食卓では、皆さまがご家庭で安心して楽しい食卓を囲めるように、アルコール除菌による清潔なキッチンの環境作りを推進してまいります。
■『アルコール除菌 ラボ@キッチン&食卓』とは
アルコール除菌 ラボ@キッチン&食卓は、一般家庭のキッチンや食卓における衛生意識を高め、清潔なキッチンのためのアルコール除菌の実践方法を伝えていくことを目的に設立された研究所です。梅雨や夏は食べ物が傷みやすく、食中毒の話題も多くなり、特に細菌性食中毒の発生件数は夏場ピークを迎えます。当研究所では、こうした時期に、ウェブサイトを通じ、アルコール除菌スプレーの使い方をはじめ、キッチンや食卓の衛生管理に役立つ様々な情報を発信しています。
URL : http://alcohol-jokin.com/
対応端末: PC/スマートフォン
<主なコンテンツ>
(1) アルコール除菌 ラボ@キッチン&食卓とは
アルコール除菌の実践方法やアルコール除菌活用のメリット、当研究所の活動目的などを紹介
(2) プロも実践!アルコール除菌
料理研究家や家事アドバイザー、飲食店などキッチンの衛生管理を徹底的に行っている方々の雑菌対策・アルコール除菌の活用術を紹介
(3) キッチン&食卓の雑菌研究室
・雑菌繁殖movie:雑菌の繁殖する様子や高濃度アルコール除菌剤によって雑菌の活動が止まる様子を紹介
・研究レポート:衛生微生物研究センターと共同で行った各種調査、実験結果を公開
(4) ニュースリリース
アルコール除菌 ラボ@キッチン&食卓の最新の情報をお知らせ
(5) お役立ちリンク
食品衛生管理や食中毒予防についてのお役立ちリンク集
■実験協力:衛生微生物研究センターについて
衛生微生物研究センター(所長:李 憲俊 所在地:東京都葛飾区)は、汚染微生物分析試験、保存効力試験(チャレンジテスト)、微生物限度試験、抗菌抗カビ試験、カビ抵抗性試験、最小発育阻止濃度(MIC)試験、空中浮遊微生物分析試験、一般生菌数測定試験、消臭試験、その他の微生物関連試験などを行っている民間の研究機関です。